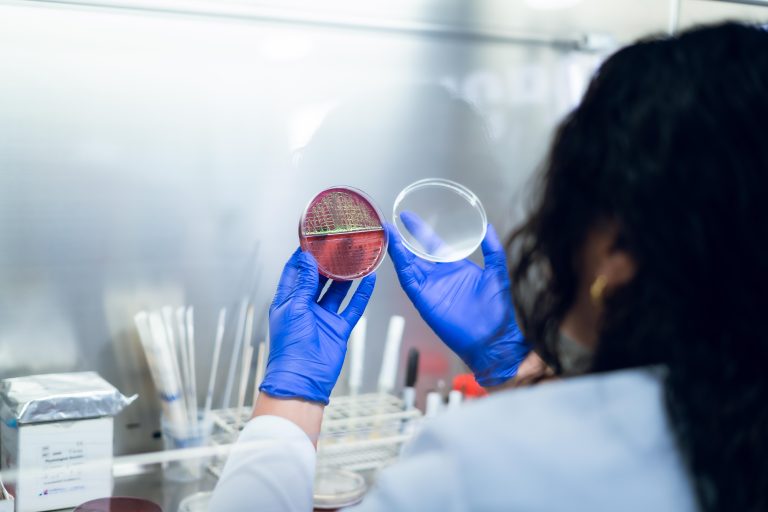

Conoce Nuestros Servicios*
*A continuación, haz clic sobre el nombre de cada área de servicio, para que se te despliegue la información de cada una.
Bioquímica Clínica
Nuestra tecnología automatizada en esta área nos ha permitido avanzar en calidad.


Cumplimos con estándares internacionales, comparando nuestros resultados con muchos laboratorios a nivel mundial.
Trabajamos con la mejor tecnología en análisis clínicos.
Hematología y Coagulación
Nuestros equipos automatizados mediante citometría de flujo con fluorescencia e impedancia con enfoque hidrodinámico y fotometria, permite realizar recuentos hematológicos y de coagulación de la más alta calidad.


Trabajamos con la mejor tecnología en análisis clínicos.
Uroanálisis y Parasitología
Nuestros análisis de rutina semiautomatizados permiten evaluar indicadores de vital importancia en el estado de salud del paciente.


Trabajamos con la mejor tecnología en análisis clínicos.
Microbiología
Hemos avanzado con educación continua en el aislamiento y cultivo de microorganismos, mediante una rápida identificación bioquímica de géneros y especies, vigilando la resistencia antimicrobiana, punto clave en el uso correcto de antibióticos para el médico y el paciente.

Trabajamos con la mejor tecnología en análisis clínicos.
Inmunología
A través de tecnología de vanguardia es posible la detección de procesos infecciosos, alérgicos o auto inmunes.
Así como la detección de desordenes metabólicos con medición de hormonas y marcadores tumorales para la detección precoz de cáncer.


Trabajamos con la mejor tecnología en análisis clínicos.
Biología Molecular
La Tecnología de nuestros Equipos de PCR en Tiempo real permite detectar el material genético de Virus y Bacterias con mayor precisión que los métodos convencionales.



Trabajamos con la mejor tecnología en análisis clínicos.
Trabajo a Domicilio
Desplazamos personal asistencial hasta su domicilio para realizar una toma de muestras más cómoda, que se ajuste a sus necesidades, y con la misma calidad que nos caracteriza.



<Trabajamos con los mejores equipos de la industria>
(Pendiente de mandar este título)
Plataforma Web de Envío de Resultados
Enviamos sus resultados por correo electrónico ó accediendo a nuestra plataforma Labdata web, en la comodidad de su hogar u oficina, para que evite movilizarse y ahorrar tiempo.


Trabajamos con la mejor tecnología en análisis clínicos.
Salud Ocupacional
(SERVICIO A EMPRESAS)
Con el objetivo de facilitar a las Empresas el monitoreo de la salud de su personal, apoyamos en la realización de exámenes de ingreso, control y egreso de empleados, desplazando nuestro personal asistencial al domicilio de la Empresa.

Trabajamos con la mejor tecnología en análisis clínicos.
